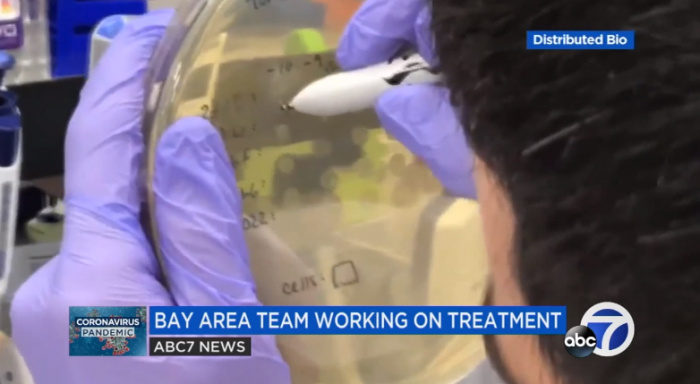
LADKGNC5H7O2F9SRG2`~AJ1.png

据外媒BGR报道,疫苗是唯一可以阻止我们感染新型冠状病毒的药物。目前已经有100多个候选疫苗正在研究中,其中有一小部分已经进入了人体试验的不同阶段。虽然种种迹象都很有希望,但我们还没有了解到这些药物是否安全有效。一旦它们被批准使用,要想让全球所有的人都得到免疫,还需要几年的时间。值得庆幸的是,目前有一种新型药物正在研发中--一种可以改善现有患者的病情,甚至可以提供有限的免疫力来抵抗感染的药物。
这些药物是以抗体为基础的药物,可以阻断SARS-CoV-2病毒在体内的复制,可以提高COVID-19患者的免疫反应。
首批成功的抗体疗法使用的是来自COVID-19康复患者的血浆。从已经康复的人身上移植到挣扎着要摆脱感染的人身上的抗体已经挽救了生命。但输血浆并不能满足需求,这时基于抗体的药物就出现了。一系列报道详细介绍了美国、韩国、中国和其他地区已经在开发的各种此类项目。有些将很快进入临床试验阶段,首批药物可能在今年晚些时候就可以投入使用。研究人员已经使用了各种可以阻止病毒复制的抗体,包括近20年前对SARS病毒起作用的抗体,以及从骆驼身上提取的抗体,这些抗体对COVID-19免疫。
ABC新闻的一篇新报道详细介绍了湾区一个团队的工作,该团队一直在研究一种抗体疗法,可能很快就可以大规模使用。该实验室也一直在使用SARS抗体来对抗这种新病毒。“一旦我们手中有了这种疗法,如果你不得不去医院,或者你的亲人不得不去医院,你可以给他们提供这种疗法,而不是让他们病得更重,面临死亡的风险,他们会迅速好转,然后回家。”Jacob Glanville博士说。这位医生因出现在Netflix上流媒体播放的《Pandemic》系列中而广为人知。他也是Distributed Bio和它的治疗公司Centivax的CEO。
“我们肯定需要疫苗,但疫苗需要很长时间,你不能给那些已经患病的人注射疫苗,因为疫苗往往需要四、五、六周才能生效,”他补充道。但“只要我们有了抗体疗法,我们就可以结束危机。”
斯坦福大学和另外两个独立实验室证实,多种Centivax SARS抗体也能中和SARS-CoV-2。这意味着,药物可以阻止新型冠状病毒与人体细胞结合并感染人体细胞。Centivax希望在8月进入临床试验,可能的治疗方法可能在9月发布,目前正在等待监管部门的批准。